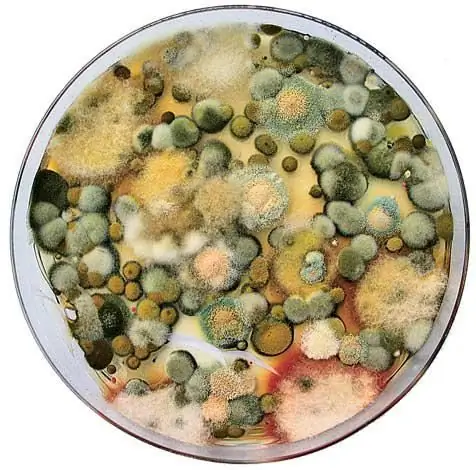

Формы везде. Ученым известно более 100 000 видов. Около ста видов грибов встречаются в виде плесени в квартире. В небольших количествах грибковые споры не представляют угрозы для здоровых людей. Но риск для здоровья возрастает с увеличением их концентрации в воздухе. Грозят хронические заболевания, грибок не удаляется.
Плесень вызывает серьезные проблемы со здоровьем, если она не обнаружена и не устранена на ранней стадии. Люди часто жалуются на головные боли, аллергию, респираторные заболевания и ревматические заболевания в загрязненных помещениях. Если эти симптомы возникают часто, квартиру следует осмотреть после грибковой инфекции. Особенно, когда жалобы исчезают из вашего собственного жизненного пространства после долгого отсутствия.

Плесень в квартире: что это?
Грибы не животные, но и не растения. Потому что они не делают фотосинтез. Вам не нужен свет, чтобы расти. Вместо этого они питаются органическим веществом. Квартира предлагает все необходимое для плесени: средние температуры, волокна обоев, чешуйки кожи, волосы и пыль, как пищу и воду. Признаками вредной влаги в доме являются затхлый затхлый запах или повышенная встречаемость древесных вшей или серебрянки. Еще один признак роста плесени: влажные пятна темного цвета на стенах, потолках и мебели.
Конструкция и неправильное использование способствуют появлению плесени

Сегодня дома строятся все более герметичными. Правила энергосбережения, меры по теплоизоляции и новые окна пропускают все меньше и меньше воздуха в дом, но также и меньше. Влажный воздух, который ранее выходил через негерметичные соединения, сегодня остается в здании. Водяной пар из воздуха затем конденсируется на холодных стенах и увлажняет стену. Относительная влажность в жилых комнатах должна составлять от 40 до 60 процентов. Гигрометр надежно измеряет степень насыщения воздуха помещения водой (паром).
Избегайте плесени эффективно
Лучшая мера предосторожности против всех видов плесени - правильная вентиляция. Цель состоит в том, чтобы заменить влажный воздух в помещении более сухим воздухом. Таким образом, средства к существованию гриба забираются.

ВЕНТИЛЯЦИЯ СОВЕТА: Полный обмен комнатного воздуха занимает до 60 минут при наклонном окне. Особенно зимой софиты и стены остывают и становятся подверженными образованию конденсата.

ВЕНТИЛЯЦИЯ ВОЗДЕЙСТВИЯ: В зависимости от силы ветра и разницы температур внутри и снаружи воздух заменяется через пять-десять минут. Затем быстро закройте окно снова.

ПЕРЕКРЕСТОЧНАЯ ВЕНТИЛЯЦИЯ: благодаря сквозняку через несколько минут в помещение поступает много свежего воздуха. Стены не остывают и снова быстро нагревают воздух.
В частности, в подвальных помещениях существует риск заражения плесенью, если они не проветриваются должным образом. Любой, кто оставляет подвальные окна открытыми летом, повреждает здание. Теплый и влажный наружный воздух встречается с холодными стенами в подвале. Воздух охлаждается и пар конденсируется на поверхностях. Потому что холодный воздух не хранит столько водяного пара, сколько теплый. Пар также конденсируется на неправильно расположенных водопроводах. Если трубы горячей воды установлены под трубами холодной воды, быстро образуется конденсированная вода: влажный воздух поднимается из теплых труб, проходит мимо холодных труб, и водяной пар из воздуха конденсируется. Негерметичные соединения труб и стеновые отверстия являются дополнительными причинами повреждения влаги в подвале.
Жить здоровой

Быстрая вентиляция снижает риск появления плесени
На вопрос о том, зачем нужна вентиляция, просто отвечают: при приготовлении пищи, уборке или даже дыхании создается влажность воздуха. Это…
Институт Строительной Физики им. Фраунгофера установил, что 40% исследуемого ущерба от влаги были вызваны строительными дефектами. Треть случаев плесени были из-за неправильного использования и поведения вентиляции.
Удалить плесень

Спреи предлагают быструю помощь против пятен плесени. Они просто распыляются на сухую, необработанную область. Содержащиеся фунгициды (фунгицидные яды) борются с плесенью глубоко в штукатурном слое во время выдержки. Не протирайте пятно заранее. Потому что это закрывает поры материала, в которые затем не проникает ни один активный ингредиент. При наличии хлорсодержащих спреев пятно на стене также отбеливается. Но будьте осторожны: пары хлора токсичны. Используйте только в хорошо проветриваемых помещениях. Альтернативы без хлора также подходят для детских комнат.

При удалении пятен от плесени вы всегда должны защищать себя защитной одеждой (дыхательная маска, перчатки, рабочие очки) от контакта с опасными грибковыми спорами. Обратите внимание на работу с низким содержанием пыли. Проветривать комнаты достаточно. Никогда не вытирайте сухую форму. Споры только поднимаются и загрязняют воздух в комнате. Влажные обои перед зачисткой. Лучше: покройте пораженную область клейкой пленкой. Следует проконсультироваться со специализированными компаниями для проведения особенно масштабных ремонтных работ. Они используют специальные пылесосы, которые пылесосят пыль и споры. Страдающие аллергией, астматики, люди с ослабленной иммунной системой, беременные женщины и дети не должны помогать бороться с плесенью.
Жить здоровой

Удалить плесень
Если в доме есть плесень, вы должны удалить ее - и прежде всего устранить причину
Если удаляется только плесень и причина образования влаги не устраняется, гриб продолжает возвращаться. Формы чрезвычайно жизнеспособны. Даже после долгого сухого сезона гриб снова оживает, когда он снова намокнет. Однако, если вы хотите удалить плесень естественным путем, вы можете зажечь пораженные участки. Сначала поврежденную стену тщательно очищают механическим способом. Обои и, возможно, даже штукатурка удаляются по всей площади, покрытой плесенью. Затем кладка нагревается с помощью пистолета горячего воздуха. Сжигать органические остатки пасты и обоев. Грибок тоже убит. Внимание: Комната должна быть очищена заранее, чтобы мебель и шторы не загорелись. Только после этого стену очищают жесткой метлой от остатков горения, а затем протирают участок спиртом.
Жить здоровой

Пресс-формы
Не отрывайте целые обои при подозрении: если они затхлые, тесты на плесень обеспечивают ясность
Предотвратить рост плесени снова
Высокие шкафы, тяжелые шторы и большие картины не следует размещать непосредственно на холодных наружных стенах. Если в комнате нет другого пространства, между стеной и предметом мебели должно быть достаточно места. От пяти до десяти сантиметров достаточно для циркуляции воздуха и предотвращения образования влаги. После того, как текстиль или мебель были заражены плесенью, их следует утилизировать. Лечение реставратором является сложным и дорогостоящим. Это часто стоит только с особенно ценной, исторической мебелью.
Продолжить "Жизнь без загрязнителей" >>
Фотографии: архив, производитель, Isofloc, Siegenia Aubi
Источник: сам человек